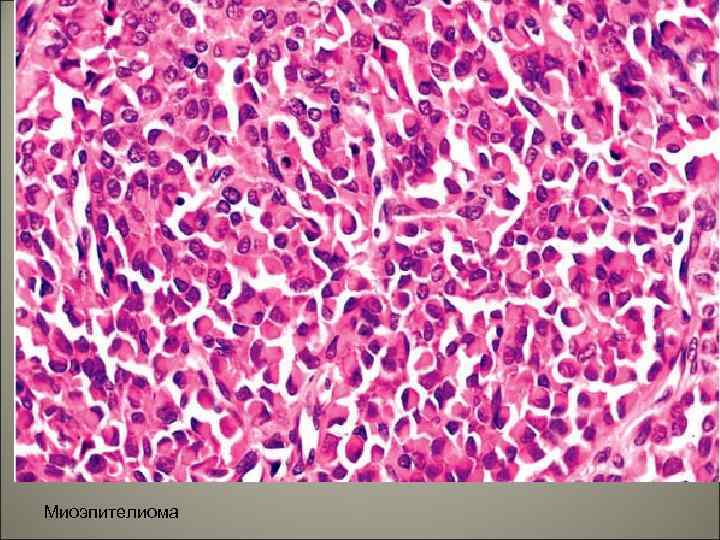
Миоэпителиома

Лекция 18 Патология слюнных желез. 1
Лекция 18 Патология слюнных желез. 1
 • Слюнные железы делятся на большие (околоушные, поднижнечелюстные, подъязычные) и малые, расположенные в различных отделах слизистой оболочки и органах полости рта (губные, язычные, щечные и др. ) По характеру секрета, который они выделяют в полость рта, железы делятся на слизистые, белковые и смешанные.
• Слюнные железы делятся на большие (околоушные, поднижнечелюстные, подъязычные) и малые, расположенные в различных отделах слизистой оболочки и органах полости рта (губные, язычные, щечные и др. ) По характеру секрета, который они выделяют в полость рта, железы делятся на слизистые, белковые и смешанные.
 • Наиболее крупные из больших желез – околоушные – являются белковыми. Средние по размеру, поднижнечелюстные – смешанные, с преобладанием белковых ацинусов, наименьшие из них – подъязычные – тоже смешанные, но с преобладанием слизистых ацинусов. Малые слюнные железы практически все – чисто слизистого строения. Исключение составляют малые, белковые железы кончика языка.
• Наиболее крупные из больших желез – околоушные – являются белковыми. Средние по размеру, поднижнечелюстные – смешанные, с преобладанием белковых ацинусов, наименьшие из них – подъязычные – тоже смешанные, но с преобладанием слизистых ацинусов. Малые слюнные железы практически все – чисто слизистого строения. Исключение составляют малые, белковые железы кончика языка.
 Околоушная слюнная железа Подчелюстная слюнная железа Подъязычная слюнная железа
Околоушная слюнная железа Подчелюстная слюнная железа Подъязычная слюнная железа
 • Все большие слюнные железы состоят из концевых отделов и системы выводных протоков. Среди эпителиальных клеток, выстилающих ацинусы и мелкие протоки, имеется особый вид клеток, содержащих в цитоплазме – миофибриллы – миоэпителиальные клетки. Эти клетки способствуют продвижению секрета из концевых отделов. • В состав каждой железы входит соединительнотканная строма.
• Все большие слюнные железы состоят из концевых отделов и системы выводных протоков. Среди эпителиальных клеток, выстилающих ацинусы и мелкие протоки, имеется особый вид клеток, содержащих в цитоплазме – миофибриллы – миоэпителиальные клетки. Эти клетки способствуют продвижению секрета из концевых отделов. • В состав каждой железы входит соединительнотканная строма.

 • Воспалительные поражения слюнных желез (сиалоадениты). • Сиалоаденит может быть самостоятельным (первичным) заболеванием, но чаще является осложнением или основным проявлением другого заболевания (вторичный сиалоаденит). • Пути проникновения инфекции в слюнные железы: интрадуктальный (по протокам из полости рта), лимфогенный, гематогенный. Чаще поражаются околоушные железы, реже поднижнечелюстные и очень редко подъязычные. По течению выделяют острый и хронический сиалоаденит. По этиологии – вирусный и бактериальный.
• Воспалительные поражения слюнных желез (сиалоадениты). • Сиалоаденит может быть самостоятельным (первичным) заболеванием, но чаще является осложнением или основным проявлением другого заболевания (вторичный сиалоаденит). • Пути проникновения инфекции в слюнные железы: интрадуктальный (по протокам из полости рта), лимфогенный, гематогенный. Чаще поражаются околоушные железы, реже поднижнечелюстные и очень редко подъязычные. По течению выделяют острый и хронический сиалоаденит. По этиологии – вирусный и бактериальный.
 • Острый вирусный эпидемический паротит вызывается РНК-содержащим вирусом. Путь передачи воздушнокапельный. Заболевание чаще встречается в детском возрасте. Входными воротами является слизистая оболочка рта и носа. При развитии вирусемии, возбудитель попадает в околоушные железы. • Макроскопически при эпидемическом паротите наблюдается резкое увеличение обеих околоушных желез. • Микроскопически в эпителиальных клетках ацинусов и клетках мелких выводных протоков отмечаются выраженные обратимые и необратимые изменения. В межуточной ткани возникает серозное и серознофибринозное воспаление. Исход: как правило, полная репаративная регенерация. Осложнения: орхит, оофорит, серозный менингит.
• Острый вирусный эпидемический паротит вызывается РНК-содержащим вирусом. Путь передачи воздушнокапельный. Заболевание чаще встречается в детском возрасте. Входными воротами является слизистая оболочка рта и носа. При развитии вирусемии, возбудитель попадает в околоушные железы. • Макроскопически при эпидемическом паротите наблюдается резкое увеличение обеих околоушных желез. • Микроскопически в эпителиальных клетках ацинусов и клетках мелких выводных протоков отмечаются выраженные обратимые и необратимые изменения. В межуточной ткани возникает серозное и серознофибринозное воспаление. Исход: как правило, полная репаративная регенерация. Осложнения: орхит, оофорит, серозный менингит.
 Острый вирусный паротид
Острый вирусный паротид
 • Цитомегаловирусный сиалоаденит вызывается ДНКсодержащим вирусом группы herpes. Инфекция поражает детей раннего возраста, у взрослых бывает реже, протекает латентно. При локализованной форме чаще поражаются околоушные слюнные железы. Макроскопически слюнные железы увеличены. Микроскопически наблюдаются весьма характерные изменения клеток ацинусов и выводных протоков, выраженные резким увеличением некоторых клеток и их ядер с формированием вокруг ядер ободков просветления ( «совиный глаз» ). В строме отмечается воспалительная гистиоцитарная инфильтрация. Исход: как правило, в той или иной степени выраженный склероз слюнной железы. При генерализованной цитомегалии, помимо слюнных желез, поражаются печень, почки, поджелудочная железа, легкие, головной мозг.
• Цитомегаловирусный сиалоаденит вызывается ДНКсодержащим вирусом группы herpes. Инфекция поражает детей раннего возраста, у взрослых бывает реже, протекает латентно. При локализованной форме чаще поражаются околоушные слюнные железы. Макроскопически слюнные железы увеличены. Микроскопически наблюдаются весьма характерные изменения клеток ацинусов и выводных протоков, выраженные резким увеличением некоторых клеток и их ядер с формированием вокруг ядер ободков просветления ( «совиный глаз» ). В строме отмечается воспалительная гистиоцитарная инфильтрация. Исход: как правило, в той или иной степени выраженный склероз слюнной железы. При генерализованной цитомегалии, помимо слюнных желез, поражаются печень, почки, поджелудочная железа, легкие, головной мозг.
 • Острый бактериальный сиалоаденит часто сопрвождает сахарный диабет, а также инфекционные болезни (тиф и др. ) Путь попадания инфекции – восходящий интраканаликулярный (по протокам) и гематогенный. Макроскопически характеризуется некоторым увеличением слюнной железы. Микроскопически – развитием гнойного воспаления, часто с абсцедированием. Осложнения: распространение гнойного воспаления за пределы железы с развитием флегмоны клетчатки челюстно-лицевой области.
• Острый бактериальный сиалоаденит часто сопрвождает сахарный диабет, а также инфекционные болезни (тиф и др. ) Путь попадания инфекции – восходящий интраканаликулярный (по протокам) и гематогенный. Макроскопически характеризуется некоторым увеличением слюнной железы. Микроскопически – развитием гнойного воспаления, часто с абсцедированием. Осложнения: распространение гнойного воспаления за пределы железы с развитием флегмоны клетчатки челюстно-лицевой области.
 • Хронический сиалоаденит может быть осложнением инфекционных заболеваний, слюннокаменной болезни (сиалолитиаза). Нередко возникает как самостоятельное заболевание невыясненной этиологии.
• Хронический сиалоаденит может быть осложнением инфекционных заболеваний, слюннокаменной болезни (сиалолитиаза). Нередко возникает как самостоятельное заболевание невыясненной этиологии.
 203. Хронический сиалоаденит
203. Хронический сиалоаденит
 • Слюннокаменная болезнь (сиалолитиаз). Характеризуется образованием конкрементов (камней) в протоках. Этиология – дискинезия, стриктуры или сдавление протоков (нарушение оттока слюны), нарушение состава слюны с увеличением в ней белков, фосфатов и карбонатов кальция и нередко хронический сиалоаденит, который в этом случае приобретает характер калькулезного.
• Слюннокаменная болезнь (сиалолитиаз). Характеризуется образованием конкрементов (камней) в протоках. Этиология – дискинезия, стриктуры или сдавление протоков (нарушение оттока слюны), нарушение состава слюны с увеличением в ней белков, фосфатов и карбонатов кальция и нередко хронический сиалоаденит, который в этом случае приобретает характер калькулезного.
 • Патогенез обусловлен взаимодействием пречисленных этиологических факторов: при застое в протоках слюны, имеющей повышенную вязкость и повышенное содержание белков и солей. Соли начинают кристаллизоваться и выпадать на белковом матриксе, формируя конкременты. Этому способствует хронический воспалительный процесс, усугубляющий как дискинетические явления, так и нарушения состава секрета, поскольку к слюне прибавляется воспалительный экссудат.
• Патогенез обусловлен взаимодействием пречисленных этиологических факторов: при застое в протоках слюны, имеющей повышенную вязкость и повышенное содержание белков и солей. Соли начинают кристаллизоваться и выпадать на белковом матриксе, формируя конкременты. Этому способствует хронический воспалительный процесс, усугубляющий как дискинетические явления, так и нарушения состава секрета, поскольку к слюне прибавляется воспалительный экссудат.
 • Микроскопически изменения характеризуются наличием диффузного воспаления продуктивного характера (диффузный интерстициальный сиалоаденит). Воспаление часто обостряется, становится гнойным. Протоки заметно расширены, по ходу стромы в стенке протоков отмечается картина склероза. В сохранившихся дольках видны явления регенерационной гиперплазии.
• Микроскопически изменения характеризуются наличием диффузного воспаления продуктивного характера (диффузный интерстициальный сиалоаденит). Воспаление часто обостряется, становится гнойным. Протоки заметно расширены, по ходу стромы в стенке протоков отмечается картина склероза. В сохранившихся дольках видны явления регенерационной гиперплазии.
 Во круг камней в Вартоновом протоке наблюдается выраженное хроническое воспаление.
Во круг камней в Вартоновом протоке наблюдается выраженное хроническое воспаление.
 • Исход: процесс практически необратим. При слюннокаменной болезни необходимо удаление пораженной слюнной железы. В случаях, когда железа не удалена, с течением времени в ней развиваются цирротические изменения с резким нарушением экскреторной и инкреторной функций. Поскольку хроническое воспаление в пораженной железе имеет тенденцию к обострению, имеется риск абсцедирования с прорывом абсцесса в окружающие ткани и развитием обширной флегмоны.
• Исход: процесс практически необратим. При слюннокаменной болезни необходимо удаление пораженной слюнной железы. В случаях, когда железа не удалена, с течением времени в ней развиваются цирротические изменения с резким нарушением экскреторной и инкреторной функций. Поскольку хроническое воспаление в пораженной железе имеет тенденцию к обострению, имеется риск абсцедирования с прорывом абсцесса в окружающие ткани и развитием обширной флегмоны.
 • Особую группу заболеваний слюнных желез составляют аутоиммунные поражения при ревматических болезнях, хроническом вирусном гепатите и струме Хашимото, синдроме Шегрена и синдроме Микулича (сухой синдром).
• Особую группу заболеваний слюнных желез составляют аутоиммунные поражения при ревматических болезнях, хроническом вирусном гепатите и струме Хашимото, синдроме Шегрена и синдроме Микулича (сухой синдром).
 • Для сухого синдрома Шегрена характерно поражение всех слюнных желез, что сопровождается ксеростомией (сухость слизистой оболочки рта), слезных желез с развитием ксерофтальмии и суставов с формированием полиартрита.
• Для сухого синдрома Шегрена характерно поражение всех слюнных желез, что сопровождается ксеростомией (сухость слизистой оболочки рта), слезных желез с развитием ксерофтальмии и суставов с формированием полиартрита.
 Синдром Шегрена сухой язык 21
Синдром Шегрена сухой язык 21
 • Этиология. Наиболее вероятным этиологическим фактором в развитии этой патологии являются вирусы, имеющие определенную тропность к лимфоидной ткани.
• Этиология. Наиболее вероятным этиологическим фактором в развитии этой патологии являются вирусы, имеющие определенную тропность к лимфоидной ткани.
 • Патогенез. На современном этапе выделяют два основных механизма. Одним из них являются вирусы с участием протоонкогена c-myc. Характер морфологических изменений в слюнных, слезных железах и суставах идентичен, как предполагают микроскопической картине лимфом. Во втором направлении, -синдром Шегрена, - патология инфекционноаллергической природы.
• Патогенез. На современном этапе выделяют два основных механизма. Одним из них являются вирусы с участием протоонкогена c-myc. Характер морфологических изменений в слюнных, слезных железах и суставах идентичен, как предполагают микроскопической картине лимфом. Во втором направлении, -синдром Шегрена, - патология инфекционноаллергической природы.
 • Макроскопические изменения в слюнной железе ограничиваются только её увеличением, сопровождающееся уплотнением ткани. Микроскопически – все, в определенной степени укладывается в морфологическую картину аутоиммунного воспаления: очаговая лимфогистиоцитарная пролиферация стромы железы, повреждение ацинарных клеток в виде обратимых и необратимых изменений и некроза с выявление иммунных комплексов.
• Макроскопические изменения в слюнной железе ограничиваются только её увеличением, сопровождающееся уплотнением ткани. Микроскопически – все, в определенной степени укладывается в морфологическую картину аутоиммунного воспаления: очаговая лимфогистиоцитарная пролиферация стромы железы, повреждение ацинарных клеток в виде обратимых и необратимых изменений и некроза с выявление иммунных комплексов.
 • Для синдрома Микулича характерно поражение больших и малых слюнных желез и слезных желез, которые увеличиваются и уплотняются; процесс также сопровождается ксеростомией и ксерофтальмией. Поражения суставов при этом не наблюдается.
• Для синдрома Микулича характерно поражение больших и малых слюнных желез и слезных желез, которые увеличиваются и уплотняются; процесс также сопровождается ксеростомией и ксерофтальмией. Поражения суставов при этом не наблюдается.
 • Микроскопически в больших и малых слюнных железах при аутоиммунных поражениях выявляется хронической диффузное воспаление, выражающееся в массовой лимфогистиоцитарной и макрофагальной инфильтрации стромы с атрофией ацинарных отделов.
• Микроскопически в больших и малых слюнных железах при аутоиммунных поражениях выявляется хронической диффузное воспаление, выражающееся в массовой лимфогистиоцитарной и макрофагальной инфильтрации стромы с атрофией ацинарных отделов.
 Синдром Шегрена
Синдром Шегрена
 • Исход при всех этих поражениях зависит от характера течения основного заболевания, но чаще неблагоприятный: атрофия и склероз железы со снижением или выключением её функции.
• Исход при всех этих поражениях зависит от характера течения основного заболевания, но чаще неблагоприятный: атрофия и склероз железы со снижением или выключением её функции.
 • Кисты слюнных желез. Кисты чаще развиваются в малых слюнных железах. Причиной образования кист является травма выводного протока, пороки развития протоков, хронический сиалоаденит, сиалолитиаз, иногда – склероз после оперативного вмешательства. Различают ретенционные и слизистые кисты.
• Кисты слюнных желез. Кисты чаще развиваются в малых слюнных железах. Причиной образования кист является травма выводного протока, пороки развития протоков, хронический сиалоаденит, сиалолитиаз, иногда – склероз после оперативного вмешательства. Различают ретенционные и слизистые кисты.
 • Ретенционная киста. Макроскопически ретенционная киста располагается под слизистой оболочкой в виде шаровидного возвышения с четкими границами, иногда флюктуирующего. Микроскопически стенка кисты представлена соединительной тканью, выстлана уплощенным эпителием. Содержимое кисты прозрачно, при осложнении (инфицировании) киста содержит гной.
• Ретенционная киста. Макроскопически ретенционная киста располагается под слизистой оболочкой в виде шаровидного возвышения с четкими границами, иногда флюктуирующего. Микроскопически стенка кисты представлена соединительной тканью, выстлана уплощенным эпителием. Содержимое кисты прозрачно, при осложнении (инфицировании) киста содержит гной.
 • Мукоцеле (слизистая киста) макроскопически напоминает опухоль. После удаления нередко рецидивирует. Микроскопически имеет тонкую соединительнотканную стенку, в просвете – скопление слизистой жидкости и множество слизистых клеток ? ? ?
• Мукоцеле (слизистая киста) макроскопически напоминает опухоль. После удаления нередко рецидивирует. Микроскопически имеет тонкую соединительнотканную стенку, в просвете – скопление слизистой жидкости и множество слизистых клеток ? ? ?
 Мукоцеле чаще всего встречается на нижней губе в виде голубоватого куполообразного возвышения. Мукоцеле обычно флюктуирует, однако, длительносуществующие образования могут иметь плотную консистенцию.
Мукоцеле чаще всего встречается на нижней губе в виде голубоватого куполообразного возвышения. Мукоцеле обычно флюктуирует, однако, длительносуществующие образования могут иметь плотную консистенцию.
 Мукоцеле
Мукоцеле
 • Эпителиальные опухоли слюнных желез. • Доброкачественные опухоли слюнных желез составляют 54 -79%. Эпителиальные опухоли чаще поражают околоушные слюнные железы, реже малые и поднижнечелюстные слюнные железы. Подъязычные железы поражаются крайне редко. • В современной гистологической классификации опухолей слюнных желез (ВОЗ, 2005) выделено более 20 нозологических форм доброкачественных и злокачественных опухолей.
• Эпителиальные опухоли слюнных желез. • Доброкачественные опухоли слюнных желез составляют 54 -79%. Эпителиальные опухоли чаще поражают околоушные слюнные железы, реже малые и поднижнечелюстные слюнные железы. Подъязычные железы поражаются крайне редко. • В современной гистологической классификации опухолей слюнных желез (ВОЗ, 2005) выделено более 20 нозологических форм доброкачественных и злокачественных опухолей.
 • Аденомы 1. Плеоморфная аденома. 2. Миоэпителиома (миоэпителиальная аденома). 3. Базальноклеточная аденома. 4. Опухоль Уортина (аденолимфома). 5. Онкоцитома (онкоцитарная аденома). 6. Каналикулярная аденома. 7. Лимфаденома. 8. Протоковая папиллома. 9. Цистаденома.
• Аденомы 1. Плеоморфная аденома. 2. Миоэпителиома (миоэпителиальная аденома). 3. Базальноклеточная аденома. 4. Опухоль Уортина (аденолимфома). 5. Онкоцитома (онкоцитарная аденома). 6. Каналикулярная аденома. 7. Лимфаденома. 8. Протоковая папиллома. 9. Цистаденома.
 • Самой частой доброкачественной опухолью слюнных желез является плеоморфная аденома (50% всех опухолей). • Плеоморфная аденома. Опухоль чаще возникает в околоушной железе, встречается в любом возрасте, но в основном между 50 и 60 годами, растет медленно и представляет собой безболезненное образование, которое может стать очень крупным, если не проводить лечение.
• Самой частой доброкачественной опухолью слюнных желез является плеоморфная аденома (50% всех опухолей). • Плеоморфная аденома. Опухоль чаще возникает в околоушной железе, встречается в любом возрасте, но в основном между 50 и 60 годами, растет медленно и представляет собой безболезненное образование, которое может стать очень крупным, если не проводить лечение.
 Плеоморфная аденома
Плеоморфная аденома
 • Макроскопически опухоль представлена одним узлом размерами от 1 до 6 -10 см в диаметре, окруженным фиброзной капсулой. На разрезе опухоль белесоватожелтого или белесовато-серого цвета, режется с трудом в связи с наличием участков хрящеподобной ткани. Опухоль может обладать мультицентрическим ростом, тогда за пределами капсулы могут быть узелки – спутники.
• Макроскопически опухоль представлена одним узлом размерами от 1 до 6 -10 см в диаметре, окруженным фиброзной капсулой. На разрезе опухоль белесоватожелтого или белесовато-серого цвета, режется с трудом в связи с наличием участков хрящеподобной ткани. Опухоль может обладать мультицентрическим ростом, тогда за пределами капсулы могут быть узелки – спутники.
 Плеоморфная аденома
Плеоморфная аденома
 • Микроскопическое строение опухоли разнообразно. Условно по преобладанию тех или иных структур выявляют три варианта плеоморфной аденомы. • Тубулярно-трабекулярная аденома с выраженным миксоидным компонентом. Представлена эпителиальными клетками, образующими трабекулы протоковых структур с отдельными кистозными образованиями, располагающимися среди слизеподобного вещества. Иногда встречаются хрящеподобные структуры, много миоэпителиальных клеток.
• Микроскопическое строение опухоли разнообразно. Условно по преобладанию тех или иных структур выявляют три варианта плеоморфной аденомы. • Тубулярно-трабекулярная аденома с выраженным миксоидным компонентом. Представлена эпителиальными клетками, образующими трабекулы протоковых структур с отдельными кистозными образованиями, располагающимися среди слизеподобного вещества. Иногда встречаются хрящеподобные структуры, много миоэпителиальных клеток.
 Тубулярно-трабекулярный вариант плеоморфной аденомы
Тубулярно-трабекулярный вариант плеоморфной аденомы
 • Тубулярно-трабекулярная аденома с наличием хондроидного компонента. Содержит трабекулярные структуры, состоящие из эпителиальных клеток и участков гомогенной ткани интенсивно розового цвета (при окраске гематоксилинэозином), содержащих замурованные эпителиальные клетки, напоминающие хондроциты.
• Тубулярно-трабекулярная аденома с наличием хондроидного компонента. Содержит трабекулярные структуры, состоящие из эпителиальных клеток и участков гомогенной ткани интенсивно розового цвета (при окраске гематоксилинэозином), содержащих замурованные эпителиальные клетки, напоминающие хондроциты.
 Тубулярно-трабекулярная аденома с наличием хондроидного компонента.
Тубулярно-трабекулярная аденома с наличием хондроидного компонента.
 • Солидная аденома. Для неё характерно преобладание полей эпителиальных клеток, которые местами образуют тубулярные структуры. Имеются небольшие участки ослизнения. Стромальный компонент выражен незначительно.
• Солидная аденома. Для неё характерно преобладание полей эпителиальных клеток, которые местами образуют тубулярные структуры. Имеются небольшие участки ослизнения. Стромальный компонент выражен незначительно.
 Солидная аденома
Солидная аденома
 • Плеоморфная аденома с преобладанием миксоидного компонента нередко рецидивирует после удаления, что связано с неудачным оперативным вмешательством при котором тонкая капсула опухоли повреждается. Кроме того, при операциях на околоушной слюнной железе высокий риск повреждения лицевого нерва, что ограничивает действия хирурга и делает объем операции менее радикальным. Рецидивы плеоморфной аденомы чаще всего имеют солидное строение и имеют склонность к малигнизации.
• Плеоморфная аденома с преобладанием миксоидного компонента нередко рецидивирует после удаления, что связано с неудачным оперативным вмешательством при котором тонкая капсула опухоли повреждается. Кроме того, при операциях на околоушной слюнной железе высокий риск повреждения лицевого нерва, что ограничивает действия хирурга и делает объем операции менее радикальным. Рецидивы плеоморфной аденомы чаще всего имеют солидное строение и имеют склонность к малигнизации.
 • Миоэпителиальная аденома. Составляет около 4% около эпителиальных опухолей слюнных желез. Чаще локализуется в околоушной слюнной железе, встречается в старшей возрастной группе от 40 до 80 лет, чаще у женщин.
• Миоэпителиальная аденома. Составляет около 4% около эпителиальных опухолей слюнных желез. Чаще локализуется в околоушной слюнной железе, встречается в старшей возрастной группе от 40 до 80 лет, чаще у женщин.
 • Макроскопически опухоль неправильной, узловатой формы, на разрезе представлена плотной белесоватой тканью. • Микроскопически опухоль состоит из веретенообразных, полигональных, плазмоцитоидных светлых клеток, формирующих анастомозирующие тяжи и солидные клеточные скопления, расположенные в миксоидном или гиалинизированном матриксе. Микроскопически выделяют три варианта: ретикулярный с тяжами миоэпителиальных клеток и миксоидным компонентом, солидный – с комплексами из плазмоцитоидных и светлых клеток и смешанный.
• Макроскопически опухоль неправильной, узловатой формы, на разрезе представлена плотной белесоватой тканью. • Микроскопически опухоль состоит из веретенообразных, полигональных, плазмоцитоидных светлых клеток, формирующих анастомозирующие тяжи и солидные клеточные скопления, расположенные в миксоидном или гиалинизированном матриксе. Микроскопически выделяют три варианта: ретикулярный с тяжами миоэпителиальных клеток и миксоидным компонентом, солидный – с комплексами из плазмоцитоидных и светлых клеток и смешанный.
Миоэпителиома
Миоэпителиома
 • Опухоль Уортина (аденолимфома) – встречается редко (6% всех опухолей слюнной железы), преимущественно у мужчин старше 40 лет, иногда бывает двухсторонней. Представляет четко отграниченный инкапсулированный узел 25 см в диаметре.
• Опухоль Уортина (аденолимфома) – встречается редко (6% всех опухолей слюнной железы), преимущественно у мужчин старше 40 лет, иногда бывает двухсторонней. Представляет четко отграниченный инкапсулированный узел 25 см в диаметре.
 • Макроскопически на разрезе бледносерого цвета с множеством мелких, щелевидных или крупных кист, заполненных серозным содержимым. • Микроскопически железистые структуры и кистозные образования выстланы двойным слоем клеток, похожих на эпителий слюнных протоков. В строме отмечаются диффузные лимфоцитарные инфильтраты с образованием лимфоцитарных фолликулов.
• Макроскопически на разрезе бледносерого цвета с множеством мелких, щелевидных или крупных кист, заполненных серозным содержимым. • Микроскопически железистые структуры и кистозные образования выстланы двойным слоем клеток, похожих на эпителий слюнных протоков. В строме отмечаются диффузные лимфоцитарные инфильтраты с образованием лимфоцитарных фолликулов.
 Опухоль Уортина (аденолимфома)
Опухоль Уортина (аденолимфома)
 • Онкоцитома (оксифильная аденома) – редкая доброкачественная опухоль слюнных желез, возникает преимущественно в околоушной слюнной железе (менее 1% новообразований данной локализации). Встречаются двухсторонние поражения с мультицентрическим ростом у больных в возрасте от 50 до 80 лет и старше.
• Онкоцитома (оксифильная аденома) – редкая доброкачественная опухоль слюнных желез, возникает преимущественно в околоушной слюнной железе (менее 1% новообразований данной локализации). Встречаются двухсторонние поражения с мультицентрическим ростом у больных в возрасте от 50 до 80 лет и старше.
 • Макроскопически опухоль в виде узла с четкими границами, окружена капсулой, эластической консистенции, на разрезе буровато-коричневая. • Микроскопически онкоцитома представлена крупными светлыми клетками с зернистой эозинофильной цитоплазмой с небольшим ядром, формирующими солидно-альвеолярные структуры.
• Макроскопически опухоль в виде узла с четкими границами, окружена капсулой, эластической консистенции, на разрезе буровато-коричневая. • Микроскопически онкоцитома представлена крупными светлыми клетками с зернистой эозинофильной цитоплазмой с небольшим ядром, формирующими солидно-альвеолярные структуры.
 Онкоцитома
Онкоцитома
 Онкоцитома
Онкоцитома
 • Злокачественные эпителиальные опухоли. 1. Ациноклеточная карцинома. 2. Мукоэпидермоидная карцинома. 3. Аденокистозная карцинома. 4. Полиморфная аденокарцинома низкой степени злокачественности. 5. Эпителиально-миоэпителиальная карцинома. 6. Светлоклеточная карцинома. 7. Базальноклеточная аденокарцинома и др.
• Злокачественные эпителиальные опухоли. 1. Ациноклеточная карцинома. 2. Мукоэпидермоидная карцинома. 3. Аденокистозная карцинома. 4. Полиморфная аденокарцинома низкой степени злокачественности. 5. Эпителиально-миоэпителиальная карцинома. 6. Светлоклеточная карцинома. 7. Базальноклеточная аденокарцинома и др.
 • Злокачественный эпителиальные опухоли слюнных желез • Злокачественные эпителиальные опухоли составляют 21 -46%. Наиболее частой злокачественной опухолью является мукоэпидермоидная карциома.
• Злокачественный эпителиальные опухоли слюнных желез • Злокачественные эпителиальные опухоли составляют 21 -46%. Наиболее частой злокачественной опухолью является мукоэпидермоидная карциома.
 • Мукоэпидермоидная карцинома. Встречается на 5 -6 десятке жизни, чаще у женщин (1: 2, 5), но может быть и в детском возрасте. По локализации на первом месте – околоушная слюнная железа, на втором – малые слюнные железы на небе.
• Мукоэпидермоидная карцинома. Встречается на 5 -6 десятке жизни, чаще у женщин (1: 2, 5), но может быть и в детском возрасте. По локализации на первом месте – околоушная слюнная железа, на втором – малые слюнные железы на небе.
 • Макроскопически мукоэпидермоидная карцинома хорошо отграничена от окружающих тканей, но редко инкапсулирована. Чаще всего имеются множественные кисты. Консистенция опухоли варьирует от мягкой до «каменистой» . Узлы желтоватые или сероватые с коричневыми прослойками, размером от 1, 5 до 4 см.
• Макроскопически мукоэпидермоидная карцинома хорошо отграничена от окружающих тканей, но редко инкапсулирована. Чаще всего имеются множественные кисты. Консистенция опухоли варьирует от мягкой до «каменистой» . Узлы желтоватые или сероватые с коричневыми прослойками, размером от 1, 5 до 4 см.
 Мукоэпидермоидная карцинома хорошо отграничена от окружающих тканей, инкапсулирована, имеются множественные кисты, опухолевые узлы желтоватые.
Мукоэпидермоидная карцинома хорошо отграничена от окружающих тканей, инкапсулирована, имеются множественные кисты, опухолевые узлы желтоватые.
 • Микроскопически мукоэпидермоидная карцинома подразделяется на опухоли высокой, умеренной и низкой степени злокачественности. • К высокодифференцированным относят опухоли, в которых клеточный состав представлен эпидермоидными клетками с большой примесью клеток, секретирующих слизь и слизистыми кистами. Клеточный полиморфизм и патологические фигуры митоза не выражены. Эта форма опухоли обладает медленным ростом.
• Микроскопически мукоэпидермоидная карцинома подразделяется на опухоли высокой, умеренной и низкой степени злокачественности. • К высокодифференцированным относят опухоли, в которых клеточный состав представлен эпидермоидными клетками с большой примесью клеток, секретирующих слизь и слизистыми кистами. Клеточный полиморфизм и патологические фигуры митоза не выражены. Эта форма опухоли обладает медленным ростом.
 Мукоэпидермоидная карцинома
Мукоэпидермоидная карцинома
 • В мукоэпидермоидной карциноме умеренной степени злокачественности меньше кист, они имеют меньший размер, выявляются обширные поля эпидермоидных клеток, клеток секретирующих слизь – мало.
• В мукоэпидермоидной карциноме умеренной степени злокачественности меньше кист, они имеют меньший размер, выявляются обширные поля эпидермоидных клеток, клеток секретирующих слизь – мало.
 • В группу низкодифференцированных отнесены те мукоэпидермоидные карциномы, в которых выражен клеточный полиморфизм, имеются патологические митозы, резкий гиалиноз стромы единичные мелкие кисты. Клеточный состав представлен промежуточными и эпидермоидными элементами. Метастазирует опухоль, в основном лимфогенно.
• В группу низкодифференцированных отнесены те мукоэпидермоидные карциномы, в которых выражен клеточный полиморфизм, имеются патологические митозы, резкий гиалиноз стромы единичные мелкие кисты. Клеточный состав представлен промежуточными и эпидермоидными элементами. Метастазирует опухоль, в основном лимфогенно.
 Низкодифференцированная мукоэпидермоидная карцинома
Низкодифференцированная мукоэпидермоидная карцинома
 • Аденокистозная карцинома (цилиндрома) составляет от1, 2 до 10% всех злокачественных опухолей слюнных желез и является второй по частоте карциномой слюнных желез. Преимущественная локализация – малые слюнные железы, главным образом в области неба, околоушная железа. Чаще встречается у женщин (1: 1, 6) в возрасте 60 -70 лет, а у молодых встречается чрезвычайно редко. Аденокистозная карцинома растет медленно, но рано дает инвазивный рост. Характерный инвазивный рост – вдоль оболочек нервов с болевым синдромом.
• Аденокистозная карцинома (цилиндрома) составляет от1, 2 до 10% всех злокачественных опухолей слюнных желез и является второй по частоте карциномой слюнных желез. Преимущественная локализация – малые слюнные железы, главным образом в области неба, околоушная железа. Чаще встречается у женщин (1: 1, 6) в возрасте 60 -70 лет, а у молодых встречается чрезвычайно редко. Аденокистозная карцинома растет медленно, но рано дает инвазивный рост. Характерный инвазивный рост – вдоль оболочек нервов с болевым синдромом.
 • Макроскопически опухоль представлена плотными узлами диаметром от 1 до 4 -5 см, на разрезе серовато-желтая, с нечеткими границами. • По морфологической структуре выделены три формы: криброзная, тубулярная и солидна.
• Макроскопически опухоль представлена плотными узлами диаметром от 1 до 4 -5 см, на разрезе серовато-желтая, с нечеткими границами. • По морфологической структуре выделены три формы: криброзная, тубулярная и солидна.
 • Для криброзной формы характерным является формирование решетчатых (криброзных) структур из эпителиальных и миоэпителиальных клеток, среди которых имеется множество мелких кист, содержащих PAS-положительное вещество.
• Для криброзной формы характерным является формирование решетчатых (криброзных) структур из эпителиальных и миоэпителиальных клеток, среди которых имеется множество мелких кист, содержащих PAS-положительное вещество.
 Криброзная форма аденокистозной карциномы Солидный вариант аденокистозной карциномы
Криброзная форма аденокистозной карциномы Солидный вариант аденокистозной карциномы
 • Тубулярный вариант представлен протокоподобными структурами и стромой с выраженным гиалинозом. • Солидный вариант представлен обширными полями кубовидных клеток, строма с явлениями гиалиноза. Криброзные структуры выражены слабо.
• Тубулярный вариант представлен протокоподобными структурами и стромой с выраженным гиалинозом. • Солидный вариант представлен обширными полями кубовидных клеток, строма с явлениями гиалиноза. Криброзные структуры выражены слабо.
 • Прогноз зависит от морфологического варианта. Солидный вариант дает наиболее высокий процент рецидивов после удаления. • Метастазирует аденокистозная карцинома гематогенным путем в легкие, при локализации на небе, может проникать по черепным нервам в полость черепа.
• Прогноз зависит от морфологического варианта. Солидный вариант дает наиболее высокий процент рецидивов после удаления. • Метастазирует аденокистозная карцинома гематогенным путем в легкие, при локализации на небе, может проникать по черепным нервам в полость черепа.
 • Карцинома в плеоморфной аденоме составляет от 1, 5 до 6% всех опухолей слюнных желез и от 15 до 20% среди злокачественных новообразований данной локализации. Средний возраст больных приблизительно на 10 лет старше, чем у пациентов с плеоморфной аденомой. У больных обнаруживается болезненное плотное образование, паралич лицевого нерва.
• Карцинома в плеоморфной аденоме составляет от 1, 5 до 6% всех опухолей слюнных желез и от 15 до 20% среди злокачественных новообразований данной локализации. Средний возраст больных приблизительно на 10 лет старше, чем у пациентов с плеоморфной аденомой. У больных обнаруживается болезненное плотное образование, паралич лицевого нерва.
 • Макроскопически опухоль представляет отдельный узел диаметром до 3 см, либо конгломерат узлов с нечеткими границами диаметром до 14 см, на разрезе желтосерого цвета. • Микроскопически отмечаются различные гистологические типы карцином: до 35%аденокистозная, 25% мукоэпидермоидная, 25%недифференцированная, в 15 -20% аденокарцинома. Все варианты характеризуются наличием некроза, кровоизлияний, гиалиноза стромы.
• Макроскопически опухоль представляет отдельный узел диаметром до 3 см, либо конгломерат узлов с нечеткими границами диаметром до 14 см, на разрезе желтосерого цвета. • Микроскопически отмечаются различные гистологические типы карцином: до 35%аденокистозная, 25% мукоэпидермоидная, 25%недифференцированная, в 15 -20% аденокарцинома. Все варианты характеризуются наличием некроза, кровоизлияний, гиалиноза стромы.
 Карцинома в плеоморфной аденоме околоушной слюнной железы
Карцинома в плеоморфной аденоме околоушной слюнной железы
 Карцинома в плеоморфной аденоме
Карцинома в плеоморфной аденоме
 • Полиморфная аденокарцинома низкой степени злокачественности. Подавляющее большинство этих опухолей локализуется в малых слюнных железах, 60%- в области неба.
• Полиморфная аденокарцинома низкой степени злокачественности. Подавляющее большинство этих опухолей локализуется в малых слюнных железах, 60%- в области неба.
 • Макроскопически – неинкапсулированный дольчатый узел, средний размер – 2 см, часто сопровождается изъязвлением слизистой оболочки. Опухоль обладает инфильтрирующим ростом, но крайне редко метастазирует.
• Макроскопически – неинкапсулированный дольчатый узел, средний размер – 2 см, часто сопровождается изъязвлением слизистой оболочки. Опухоль обладает инфильтрирующим ростом, но крайне редко метастазирует.
 • Спасибо за внимание
• Спасибо за внимание


